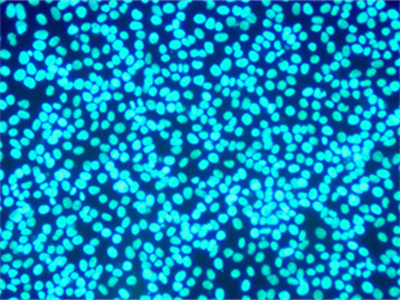
HIF1300L-3

MHIF2000-N是倒置荧光显微镜MHIF2000升级款,搭配UBG 3颗10W大功率LED荧光光源,实现清晰的、高信噪比的荧光观察,轻松实现不同通道之间的切换,亮度连续可调,具有显示屏,可数显荧光通道和光源强度,具有亮度独立记忆功能,满足不同领域的荧光检测。
MHIF2000-N是倒置荧光显微镜MHIF2000升级款,搭配UBG 3颗10W大功率LED荧光光源,实现清晰的、高信噪比的荧光观察,轻松实现不同通道之间的切换,亮度连续可调,具有显示屏,可数显荧光通道和光源强度,具有亮度独立记忆功能,满足不同领域的荧光检测。广泛使用于医疗检验、病理诊断、免疫荧光、细胞观察等领域,用来观察生物切片、生物细胞、细菌以及活体组织培养、流质沉淀等的观察和研究,同时可以观察其他透明或者半透明物体以及粉末、细小颗粒等物体。
光学系统 | 40x-400x放大倍数,无限远色差独立校正光学系统,齐焦距离为国际标准45mm | ||
照明系统 | ·内置透射照明系统,柯勒照明 | ||
·LED功耗 3W(标称),白色大功率LED灯,色温4000K,使用寿命≥20000小时 | |||
·标配蓝、绿、黄色滤色片,含滤光片板,可拆卸 | |||
·旋转式孔径光阑,手动调节 | |||
·推拉式相衬环板 | |||
调焦机构 | ·载物台高度升降范围≥14mm | ||
·低手位粗微调同轴调焦手轮 | |||
·粗调限位旋钮,避免标本或物镜的损伤 | |||
·粗调焦旋钮的张力可调节 | |||
·细调焦旋钮最小可调幅度:1μm | |||
物镜转盘 | 固定5孔物镜转换器,滚珠轴承内定位,有防霉装置 | ||
载物台 | ·机械固定载物台(W x D):200mm x 266mm,配有可替换的水滴载物片(φ110) | ||
·移动范围(X x Y):80mm x 50mm | |||
·右侧手柄平板载物台,配有可移出的样本夹 | |||
观察筒 | ·铰链式三目观察镜筒,30度倾斜,360度旋转,瞳距范围52-75mm,±5视度调节 | ||
·光路选择:目镜/相机口=100/0或0/100 | |||
目镜 | ·10X 视场数(FN)20 高眼点 | ||
·对中望远镜 | |||
聚光镜 | ·数值孔径:0.30 | ||
·工作距离:72mm | |||
·适用物镜:2倍至60倍,带有孔径光阑 | |||
长距平场消色差物镜 | ·4X PH NA 0.13 W.D. 10.43mm | ||
·10X PH NA 0.25 W.D. 7.3mm | |||
长距平场半复消色差物镜 | ·10X Fluor NA 0.30 W.D. 8.31mm | ||
·20X Fluor PH NA 0.45 W.D. 7.11mm | |||
·40X Fluor PH NA 0.65 W.D. 1.61mm | |||
荧光附件 | 最多可配置3个荧光通道,旋钮式荧光切换方式,亮度连续可调,具有显示屏,可数显荧光通道和光源强度,具有亮度独立记忆功能。12V2A电源适配器,另外配有荧光挡板 | ||
光源 | 标配UBG 3颗10W大功率LED光源,寿命30000小时以上 | ||
常用荧光通道 | 荧光激发通道 | 参数 | |
紫外带通UA | EX:365/30nm DM:405nm EM:460/50nm | ||
蓝色带通BA | EX:470/30nm DM:505nm EM:535/35nm | ||
绿色长通G | EX:530/30nm DM:565nm EM:575nmLP | ||
荧光滤光片组可根据客户实际需求优化调整,具体请咨询本公司 | |||
相机接口 | 1x接口 | ||
0.65x接口、0.5x接口(选配) | |||
额定电压/电流 | AC 100 240V 50/60Hz 0.4 A | ||

热线020-87096762

致电13418179239